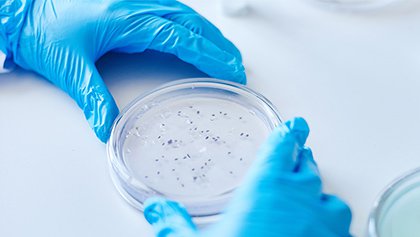

-20% Descuento en la reserva de plaza para el curso 26/27. ¡Solo hasta el 30 de junio!
Estudia la carrera de Farmacia
Título oficial emitido por Universidad Europea de Madrid
| Presencial | Clases en Español | Villaviciosa de Odón | 5 años, 300 ECTS | Inicio: 7 sep. 2026 | Facultad de Ciencias Biomédicas y de la Salud |
La farmacia es una disciplina esencial que une ciencia, salud y tecnología para garantizar el uso seguro y eficaz de los medicamentos. Su impacto transforma la vida de millones de personas a través del desarrollo, la distribución y el control de tratamientos farmacológicos.
Estudia el Grado en Farmacia en la Universidad Europea y transforma tu pasión científica en una carrera llena de oportunidades. Aprende de forma práctica y avanzada, con acceso a espacios innovadores como el hospital simulado y la farmacia comunitaria, que te prepararán para destacar en el mercado laboral desde el primer día.
Y si tu meta es el FIR, nuestra metodología ha permitido alcanzar resultados destacados, situando al 66 % de nuestros alumnos en el percentil 73 del examen FIR 2023.
Un grado en Farmacia que marca la diferencia:
- Enfoque práctico: fórmate a través de un modelo basado en la simulación de casos reales con actores, prácticas de laboratorio y prácticas externas en las empresas y organizaciones más prestigiosas del sector, como COFM, Cofares, Ercros, Lilly, Roche Pharma o Quintiles, entre otros.
- Podrás diferenciar tu perfil con el Curso de Experto en Gestión de Oficina de Farmacia y Marketing Farmacéutico, que podrás realizar de manera gratuita mientras cursas el grado.
- Tendrás acceso a instalaciones de última generación específicas para farmacéuticos, como la Farmacia Comunitaria Simulada y el Hospital Simulado con Farmacia Hospitalaria, además de laboratorios especializados en Biomedicina, Tecnología Farmacéutica, Genética, Microbiología y Biotecnología, o a aulas de bioinformática, entre otras.
- Amplía tu horizonte: consigue una doble titulación en solo un año más y obtén también el Grado en Biotecnología o en Nutrición Humana y Dietética.
Conéctate con el corazón del sector farma.
Desde el inicio de tu formación, te abrirás paso en una red de más de 400 entidades líderes como Cinfa, Pfizer, Quirónsalud, MD Anderson o Cofares. Tendrás la oportunidad de aprender junto a profesionales en activo, en farmacias, laboratorios y hospitales de referencia nacional, donde se decide el futuro de la salud. Porque aquí no solo estudias Farmacia: la vives, la practicas y la transformas desde dentro.





Solo con las mejores instalaciones se forma a los mejores farmacéuticos
Plan de estudios
Estructura del plan de estudios
Un plan de estudios diseñado desde las necesidades del sector profesional. Durante los primeros años del grado, adquirirás conocimientos más generalistas para, sucesivamente, y guiado/a por tus profesores, ir descubriendo en qué área de la farmacia te gustaría especializarte.
Con este plan de estudios aprende sobre la atención farmacéutica reforzando el conocimiento de la patología médica que permitirá ofrecer un consejo farmacéutico personalizado, para conocer cómo afecta la variabilidad genética de un individuo en su respuesta a los fármacos o para obtener así nuevos tratamientos personalizados. Conoce los últimos avances en tecnología farmacéutica y sistemas de liberación controlada de fármacos.
Gestiona de manera eficaz una Farmacia Comunitaria con el curso de Experto en Gestión de Farmacia Comunitaria y Marketing Farmacéutico que realizas junto a tus estudios de Grado.
Programa de estudios
PRIMER CURSO
| Materia | ECTS | Tipo | Idioma de impartición |
|---|---|---|---|
| Química General Farmacéutica I | 6 | BÁSICA | Español (es) |
| Química General Farmacéutica II | 3 | OBLIGATORIA | Español (es) |
| Iniciación al Trabajo de Laboratorio | 3 | OBLIGATORIA | Español (es) |
| Técnicas Instrumentales Farmacéuticas | 6 | BÁSICA | Español (es) |
| Biofísica y Físico-Química Aplicada a las Ciencias Farmacéuticas | 6 | BÁSICA | Español (es) |
| Matemáticas | 6 | BÁSICA | Español (es) |
| Informática y Tecnologías de la Información y Comunicación Aplicados a la Farmacia | 3 | OBLIGATORIA | Español (es) |
| Procesos Biológicos I | 6 | BÁSICA | Español (es) |
| Procesos Biológicos II | 6 | BÁSICA | Español (es) |
| Estructura y Función del Cuerpo Humano I | 6 | BÁSICA | Español (es) |
| Estructura y Función del Cuerpo Humano II | 6 | BÁSICA | Español (es) |
| Idioma Moderno I | 3 | OBLIGATORIA | Español (es) |
SEGUNDO CURSO
| Materia | ECTS | Tipo | Idioma de impartición |
|---|---|---|---|
| Química Orgánica I | 6 | OBLIGATORIA | Español (es) |
| Química Orgánica II | 6 | OBLIGATORIA | Español (es) |
| Análisis Químico Farmacéutico I | 6 | BÁSICA | Español (es) |
| Análisis Químico Farmacéutico II | 3 | OBLIGATORIA | Español (es) |
| Estadística y Epidemiología Aplicada a las Ciencias Farmacéuticas | 6 | BÁSICA | Español (es) |
| Botánica Farmacéutica | 3 | OBLIGATORIA | Español (es) |
| Farmacognosia | 3 | OBLIGATORIA | Español (es) |
| Parasitología | 3 | OBLIGATORIA | Español (es) |
| Microbiología I | 6 | BÁSICA | Español (es) |
| Microbiología II | 3 | OBLIGATORIA | Español (es) |
| Procesos Biológicos III: Bioquímica Farmacéutica | 6 | BÁSICA | Español (es) |
| Fisiopatología Aplicada a las Ciencias Farmacéuticas | 6 | BÁSICA | Español (es) |
| Idioma Moderno II | 3 | OBLIGATORIA | Español (es) |
TERCER CURSO
| Materia | ECTS | Tipo | Idioma de impartición |
|---|---|---|---|
| Química Farmacéutica I | 6 | OBLIGATORIA | Español (es) |
| Química Farmacéutica II | 6 | OBLIGATORIA | Español (es) |
| Genética | 6 | OBLIGATORIA | Español (es) |
| Biología Molecular | 6 | OBLIGATORIA | Español (es) |
| Bromatología | 6 | OBLIGATORIA | Español (es) |
| Inmunología | 6 | OBLIGATORIA | Español (es) |
| Farmacología I | 6 | OBLIGATORIA | Español (es) |
| Farmacología II | 6 | OBLIGATORIA | Español (es) |
| Nutrición Básica | 6 | OBLIGATORIA | Español (es) |
| Atención Farmacéutica I | 3 | OBLIGATORIA | Español (es) |
| Salud Pública | 3 | OBLIGATORIA | Español (es) |
CUARTO CURSO
| Materia | ECTS | Tipo | Idioma de impartición |
|---|---|---|---|
| Bioinformática | 6 | OBLIGATORIA | Español (es) |
| Tecnología Farmacéutica I | 6 | OBLIGATORIA | Español (es) |
| Tecnología Farmacéutica II | 6 | OBLIGATORIA | Español (es) |
| Biotecnología Farmacéutica | 6 | OBLIGATORIA | Español (es) |
| Farmacocinética | 6 | OBLIGATORIA | Español (es) |
| Farmacología III | 3 | OBLIGATORIA | Español (es) |
| Atención Farmacéutica II | 3 | OBLIGATORIA | Español (es) |
| Organización y Gestión de Empresa Farmacéutica | 3 | OBLIGATORIA | Español (es) |
| Economía | 3 | OBLIGATORIA | Español (es) |
| Análisis Biológico y Diagnóstico de Laboratorio | 6 | OBLIGATORIA | Español (es) |
| Toxicología | 6 | OBLIGATORIA | Español (es) |
| Optativa I | 6 | OPTATIVA | Español (es) |
QUINTO CURSO
| Materia | ECTS | Tipo | Idioma de impartición |
|---|---|---|---|
| Farmacogenética y Farmacogenómica | 3 | OBLIGATORIA | Español (es) |
| Tecnología Farmacéutica III | 3 | OBLIGATORIA | Español (es) |
| Ética | 3 | OBLIGATORIA | Español (es) |
| Legislación | 3 | OBLIGATORIA | Español (es) |
| Farmacoterapia y Farmacia Clínica | 6 | OBLIGATORIA | Español (es) |
| Estancias Tuteladas en Farmacia Comunitaria o Farmacia Hospitalaria | 24 | OBLIGATORIA | Español (es) |
| Trabajo Fin de Grado | 6 | OBLIGATORIA | Español (es) |
| Optativa II | 6 | OPTATIVA | Español (es) |
| Optativa III | 6 | OPTATIVA | Español (es) |
OPTATIVAS
| Materia | ECTS | Tipo | Idioma de impartición |
|---|---|---|---|
| Química Avanzada del Fármaco | 6 | OPTATIVA | Español (es) |
| Ingeniería Genética Molecular | 6 | OPTATIVA | Español (es) |
| Química e Ingeniería de Proteínas | 6 | OPTATIVA | Español (es) |
| Cultivos Celulares e Ingeniería de Tejidos | 6 | OPTATIVA | Español (es) |
| Virología Clínica | 6 | OPTATIVA | Español (es) |
| Nanotecnología | 6 | OPTATIVA | Español (es) |
| Productos Sanitarios. Productos Dermofarmacéuticos y Cosméticos | 6 | OPTATIVA | Español (es) |
| Nutrición Básica II | 6 | OPTATIVA | Español (es) |
| Nutrición Clínica y Dietética Hospitalaria | 6 | OPTATIVA | Español (es) |
| Dietética | 6 | OPTATIVA | Español (es) |
| Nutrición en Distintas Etapas de la Vida | 6 | OPTATIVA | Español (es) |
| Investigación Biomédica | 6 | OPTATIVA | Español (es) |
| Tecnología de los Alimentos y Legislación | 6 | OPTATIVA | Español (es) |
| Salud Ambiental | 6 | OPTATIVA | Español (es) |
| Actividades Universitarias | 6 | OPTATIVA | Español (es) |
| Educación Alimentaria y Comunicación Sanitaria | 6 | OPTATIVA | Español (es) |
| Prácticas en Empresas del Sector Farmacéutico I | 6 | OPTATIVA | Español (es) |
| Prácticas en Empresas del Sector Farmacéutico II | 6 | OPTATIVA | Español (es) |
Lo que aprenderás curso a curso
1
Primer curso: las bases que impulsan la biotecnología del futuro
Durante tu primer año, conocerás los fundamentos biológicos y físico-químicos que sustentan la biotecnología moderna. Comprenderás los procesos esenciales de la vida y su aplicación al ámbito farmacéutico, mientras exploras la estructura y función del cuerpo humano como cimiento del conocimiento biomédico. Además, desarrollarás competencias clave en herramientas informáticas y comunicación científica, y comenzarás a familiarizarte con las técnicas básicas de laboratorio, sentando las bases para tu futuro como biotecnólogo.
Comienza tu viaje con las herramientas que transformarán la ciencia en soluciones para la salud.
2
Segundo curso: comprender las enfermedades para transformar la salud
En el segundo año, profundizarás en el funcionamiento del cuerpo humano desde una perspectiva biotecnológica. Estudiarás la fisiopatología y los mecanismos moleculares de las enfermedades, mientras te formas en la química orgánica aplicada a la síntesis de compuestos de interés farmacéutico. También conocerás el mundo microscópico a través de la parasitología y microbiología, esenciales para el diseño de tratamientos y diagnósticos. Aprenderás técnicas avanzadas de análisis estadístico y químico, y conocerás el potencial terapéutico de los principios activos naturales mediante la botánica farmacéutica.
Da un paso firme hacia el conocimiento que transforma la salud humana.
3
Tercer curso: especialízate para marcar la diferencia
En el tercer año, te enfocarás en áreas clave que definen el presente y el futuro de la biotecnología. Dominarás la química farmacéutica aplicada al desarrollo de medicamentos, y descubrirás cómo la bromatología y la nutrición contribuyen a la salud desde una perspectiva biotecnológica. Te adentrarás en la genética y la inmunología con una visión orientada a la medicina personalizada, y comprenderás los mecanismos moleculares que explican la acción de los tratamientos. Además, te iniciarás en la salud pública y la atención farmacéutica como elementos esenciales del bienestar colectivo.
Conviértete en el especialista que la ciencia y la sociedad necesitan.
4
Cuarto curso: lleva la teoría a la práctica y crea innovación
En tu cuarto año, comenzarás a aplicar tus conocimientos a contextos reales. Te formarás en tecnología farmacéutica para el diseño de medicamentos, y aprenderás a utilizar herramientas de diagnóstico en el laboratorio biomédico. Adquirirás también una visión integral del sector gracias a los conocimientos de gestión empresarial en entornos farmacéuticos y biotecnológicos. Estudiarás toxicología y farmacocinética para evaluar la seguridad de los tratamientos, y descubrirás cómo la bioinformática impulsa la innovación en la biotecnología farmacéutica.
Transforma el conocimiento en soluciones innovadoras para el bienestar global.
5
Quinto curso: integra tu aprendizaje y da el salto al mundo profesional
En el último curso, consolidarás tu formación con una mirada profesional y aplicada. Estudiarás farmacoterapia y farmacia clínica para intervenir en el tratamiento de enfermedades, y te especializarás en farmacogenética y farmacogenómica para diseñar terapias personalizadas. Conocerás el marco legal y ético que regula la actividad farmacéutica, y realizarás prácticas tuteladas en farmacia comunitaria y hospitalaria para aplicar tus conocimientos en entornos reales. Finalmente, desarrollarás tu Trabajo de Fin de Grado con un enfoque innovador y orientado al desarrollo.
Da el paso definitivo para convertirte en un agente de cambio en la farmacia y la salud.
Más información
Curso de Experto en Gestión de Farmacia Comunitaria y Marketing Farmacéutico para Alumnos de Farmacia (Opcional)
Título propio que no forma parte del título oficial, que se puede cursar de forma opcional.
Módulo I - Adquisición de una farmacia comunitaria: legislación, impuestos, obligaciones y gastos.
Primer curso: 3 ECTS.
Preguntas importantes:
- ¿Conozco cuáles son las formas de tener una farmacia comunitaria?
- ¿Sé que es una compra, una herencia, una donación o una nueva apertura?
- ¿Conozco los impuestos que debo pagar y cuándo?
- ¿Sé qué es un préstamo, una hipoteca, una póliza de crédito, un renting o un leasing?
- ¿Cómo se financia una farmacia comunitaria?
- ¿Puedo tener una sociedad en mi farmacia comunitaria?
Temario:
- Conocimiento del sistema tributario español.
- Aprender los tipos de impuestos: directos e indirectos, así como los especiales, los dependientes de las CCAA y de las corporaciones locales. Aplicación a los tributos que afectan al farmacéutico y a la oficina de farmacia.
- Conocer la legislación acerca de la titularidad de una oficina de farmacia en España.
- Aprender las diferentes maneras de adquirir una oficina de farmacia: transmisión onerosa (compra) y transmisión gratuita (donación o sucesión). Nuevas aperturas. Fondo de comercio. Bonificaciones. Ejemplos prácticos.
- Conocimiento de la tributación de las diferentes formas de acceder a una oficina de farmacia.
- Fiscalidad de la Oficina de Farmacia. IRPF, Ganancias Patrimoniales.
- Sociedades mercantiles y su tributación.
Módulo II - Aprender la economía de una PYME: mi farmacia comunitaria.
Segundo curso: 3 ECTS.
Preguntas importantes:
- Con mis estudios, ¿estoy capacitado para gestionar una farmacia comunitaria?
- ¿Conozco los márgenes?
- ¿Sé interpretar una factura?
- ¿Qué es una PYME?
- ¿Cómo puedo hacer rentable mi negocio familiar?
- ¿Sabría organizar mis finanzas personales?
- Si soy una PYME, como generador de empleo, ¿conozco cómo contratarlos?
- ¿Sé interpretar una nómina?
- ¿Qué tipo de contrato se adapta mejor a mi farmacia comunitaria?
Temario:
- Conceptos básicos de contabilidad. Activo, Pasivo y Patrimonio Neto. Cuenta de Pérdidas y Ganancias.
- Formas de financiación y acceso al crédito. Funcionamiento de préstamos y pólizas de crédito. Cálculo de intereses.
- Gastos e inversiones. Amortizaciones.
- Conceptos básicos de costes.
- Gestión de Tesorería.
- Análisis de Márgenes y Rotación. Analizar cuándo interesa comprar una promoción.
- Convenio Colectivo para Oficinas de Farmacia.
- Nóminas. Salario, Complementos, Pagas Extra y sus devengos. Seguros Sociales.
- Cotización en el Régimen Especial de los Trabajadores por Cuenta Ajena o Autónomos. Inscripción de Empresarios. Bases de cotización.
- Cotización a la Seguridad Social. Incapacidades laborales.
- Contrato de trabajo. Tipos de contratos: indefinidos y temporales. Despidos.
- Empresas de Trabajo Temporal.
Módulo III - Responsabilidad social corporativa del farmacéutico comunitario. Servicios que puede prestar la farmacia comunitaria y la importancia del marketing farmacéutico
Tercer curso: 3 ECTS.
Preguntas importantes:
- ¿Cómo colabora el farmacéutico con el barrio? Responsabilidad social con el entorno.
- ¿Podría aplicar lo aprendido en Atención Farmacéutica en el día a día?
- ¿Qué servicios puedo ofrecer a mis pacientes? ¿Cuáles están permitidos en la legislación vigente y cuáles no?
- ¿Cómo podría implementar una Gestión de Calidad?
- ¿Cómo se financia una farmacia comunitaria?
- ¿Puedo tener una sociedad en mi farmacia comunitaria?
- ¿Tengo conocimientos de marketing para mejorar mi farmacia comunitaria?
- ¿Conozco mi competencia y cómo puedo llevar a cabo una gestión estratégica?
Temario:
- La atención farmacéutica. Un cambio de rol
- La farmacia asistencial. Servicios centrados en el paciente. ¿Remuneración de servicios en el futuro?
- Marco legal. Funciones y obligaciones
- Calidad en la Farmacia Comunitaria
- ¿Podría aplicar lo aprendido en Atención Farmacéutica en el día a día?
- Qué es el marketing y su aplicación en la oficina de farmacia
- Plan de Marketing. Estructura. Fases (Analítica, Estratégica y Táctica) e implementación.
- Análisis DAFO. Debilidades, Amenazas, Fortalezas y Oportunidades.
- Análisis de las 4 “P” del Marketing: Producto, Precio, Promoción y Distribución
- Análisis de las ventas. Política y estrategia de ventas.
- Investigación de Mercados. Estudios Cualitativos y cuantitativos. Objetivos a alcanzar y tipos de objetivos.
- Posicionamiento. Mapa de Posicionamiento.
- Comunicación. Comunicación con el equipo, los clientes. Plan de formación y comunicación. Técnicas de comunicación.
- Implementación y plan de contingencias. Asignación de tareas, recursos y plazos. Control de desviaciones y planes alternativos.
Módulo IV - La farmacia comunitaria del S.XXI, hacia la máxima rentabilidad.
Cuarto curso: 3 ECTS.
Preguntas importantes:
- ¿Podría incrementar mis ventas aplicando técnicas de gestión comercial y estratégica?
- ¿Conozco la legislación para la venta por internet?
- ¿Sé qué es un cuadro de mandos y cómo se interpreta?
- ¿Conozco la satisfacción de mis pacientes y cómo medirla?
- ¿Cómo gestiono las reclamaciones que llegan a mi farmacia?
- ¿Me planteo llevar a cabo una reforma en mi farmacia?
- ¿Sabría cómo colocar los productos de una forma que impacte, tanto en los lineales como en el escaparate?
Temario:
- Gestión Empresarial: cuadros de mando, plan de marketing, márgenes, campañas, estrategias, plan de acción.
- Gestión de Personal: selección de personal, motivación, establecimiento de incentivos, remuneraciones adicionales.
- Gestión de Clientes: satisfacción, gestión de reclamaciones, conocimiento del mercado de la zona, tipos de farmacias competidoras, puntos fuertes y débiles de nuestra farmacia, abordaje de cada tipo de cliente, captación y fidelización de clientes
- Gestión de Compras y stock: aprovisionamiento, compras a mayoristas y compras directas, criterios de compra objetiva, rentabilidad. tipos y costes del stock, procedimientos para la gestión de stocks, cálculo del punto de pedido, gestión de devoluciones.
- Gestión de lineales: cómo crear "manchas" en los lineales que atraigan a los clientes, cartelería, señalética, imagen corporativa, escaparatismo, reformas, mobiliario.
Prácticas profesionales
Las prácticas en empresas son un elemento clave en tu formación. Adquirir experiencia después de lo aprendido en tu titulación, es la mejor forma de entrar en el mercado laboral. Hay dos tipos de prácticas, las curriculares (incluidas en tu plan de estudios) y extracurriculares (las que puedes hacer de forma voluntaria).
Para realizar las prácticas curriculares en empresas, necesitarás tener el 50% de los créditos aprobado y matricular la asignatura antes de comenzar tus prácticas. Estas prácticas llevan un seguimiento por parte de la empresa y del profesor de prácticas, así como la realización de informes intermedios y finales para su evaluación.
Durante el último año, realizarás prácticas en las principales instituciones, centros de investigación y empresas del sector a nivel nacional e internacional que te permitirá poner en marcha todos los conocimientos adquiridos.
Si quieres mejorar tu experiencia laboral antes de concluir tu formación universitaria, puedes hacer prácticas extracurriculares. Podrás hacerlas en cualquier curso, pero te recordamos que las prácticas son un complemento formativo a tus estudios; por tanto, cuanto más conocimiento hayas adquirido a lo largo de la carrera, mayor provecho sacarás de la experiencia de prácticas.
Calendario de implantación del título
- Primer Curso: 2018-2019
- Segundo Curso: 2019-2020
- Tercer Curso: 2020-2021
- Cuarto Curso: 2021-2022
- Quinto Curso: 2022-2023
Plazas de nuevo ingreso
160 plazas.
Resultados de aprendizaje
Conocimientos
- CON01. Conocer los principios éticos y deontológicos según las disposiciones legislativas, reglamentarias y administrativas que rigen el ejercicio profesional, comprendiendo las implicaciones éticas de la salud en un contexto social en transformación.
- CON02. Conocer las características fisicoquímicas de las sustancias utilizadas para la fabricación de los medicamentos.
- CON03. Conocer y comprender las características de las reacciones en disolución, los diferentes estados de la materia y los principios de la termodinámica y su aplicación a las ciencias farmacéuticas.
- CON04. Conocer y comprender las propiedades características de los elementos y sus compuestos, así como su aplicación en el ámbito farmacéutico.
- CON05. Conocer y comprender la naturaleza y comportamiento de los grupos funcionales en moléculas orgánicas.
- CON06. Conocer el origen, naturaleza, diseño, obtención, análisis y control de medicamentos y productos sanitarios.
- CON07. Conocer los principios y procedimientos para la determinación analítica de compuestos: técnicas analíticas aplicadas al análisis de agua, alimentos y medio ambiente.
- CON08. Conocer las estructuras de las biomoléculas y sus transformaciones en la célula.
- CON09. Comprender la relación entre el ciclo de vida de los agentes infecciosos y las propiedades de los principios activos.
- CON10. Conocer y comprender el control microbiológico de los medicamentos.
- CON11. Conocer las propiedades de las membranas celulares y la distribución de fármacos.
- CON12. Conocer la naturaleza y comportamiento de agentes infecciosos.
- CON13. Conocer las principales rutas metabólicas que intervienen en la degradación de fármacos.
- CON14. Conocer las plantas medicinales: diversidad botánica, fisiología, uso y gestión.
- CON15. Conocer los procesos de liberación, absorción, distribución, metabolismo y excreción de fármacos, y factores que condicionan la absorción y disposición en función de sus vías de administración.
- CON16. Conocer las propiedades fisicoquímicas y biofarmacéuticas de los principios activos y excipientes, así como las posibles interacciones entre ambos.
- CON17. Conocer la estabilidad de los principios activos y formas farmacéuticas, así como los métodos de estudio.
- CON18. Conocer las operaciones básicas y procesos tecnológicos relacionados con la elaboración y control de medicamentos.
- CON19. Conocer y comprender los fundamentos básicos de los análisis clínicos y las características y contenidos de los dictámenes del diagnóstico de laboratorio.
- CON20. Conocer y comprender las técnicas utilizadas en el diseño y evaluación de los ensayos preclínicos y clínicos.
- CON21. Comprender la relación existente entre alimentación y salud, y la importancia de la dieta en el tratamiento y prevención de las enfermedades.
- CON22. Conocer y comprender la gestión y características propias de la asistencia farmacéutica en las Estructuras Asistenciales de Atención Primaria y de Atención Especializada en el Sistema Sanitario.
- CON23. Conocer las propiedades y mecanismos de acción de los fármacos.
- CON24. Conocer y comprender la estructura y función del cuerpo humano, así como los mecanismos generales de la enfermedad, alteraciones moleculares, estructurales y funcionales, expresión sindrómica y herramientas terapéuticas para restaurar la salud.
- CON25. Conocer la naturaleza, mecanismo de acción y efecto de los tóxicos, así como los recursos en caso de intoxicación.
- CON26. Conocer las técnicas analíticas relacionadas con diagnóstico de laboratorio, tóxicas, alimentos y medioambiente.
- CON27. Conocer y comprender la gestión y características propias de la asistencia farmacéutica en el ámbito oficinal y de la industria farmacéutica.
- CON28. Conocer los principios y la metodología científica aplicada a las ciencias farmacéuticas, incluyendo la historia y función social de la Farmacia.
- CON29. Tener conocimientos básicos del Sistema Nacional de Salud, de la legislación sanitaria en general y específicamente la relacionada con los medicamentos, productos sanitarios y asistencia farmacéutica.
- CON30. Conocer el funcionamiento y gestión de un servicio de farmacia hospitalaria o de atención primaria, incluido el personal adscrito a los mismos
- CON31. Identificar la normativa de trabajo de un laboratorio y las principales técnicas experimentales.
- CON32. Describir la estructura, función y características de los aparatos y sistemas del cuerpo humano en condiciones fisiológicas desde el punto de vista celular, tisular y orgánico.
- CON33. Reconocer las diferentes formas de vida microscópica y su relación con el ser humano.
- CON34. Describir las funciones del farmacéutico como agente de salud respetando los principios básicos de la ética profesional y la legislación vigente en el ambiente comunitario y hospitalario
- CON35. Clasificar los mecanismos de acción, origen, características e indicaciones de los diferentes principios activos y/o productos sanitarios destinados al tratamiento de enfermedades
- CON36. Clasificar la estructura y propiedades físico-químicas de los diferentes compuestos químicos
- CON37. Describir las bases moleculares, las principales dianas terapéuticas implicadas en el desarrollo de enfermedades y/o los mecanismos fisiológicos y manifestaciones clínicas de las diferentes patologías
- CON38. Definir las diferentes funciones matemáticas y/o los tipos de estudios epidemiológicos y su implicación en las ciencias farmacéuticas.
- CON39. Identificar los diferentes sistemas operativos y su aplicación en las ciencias farmacéuticas
- CON40. Clasificar el origen, características, tipos y utilidad de los diferentes nutrientes y/o alimentos y su relación con las diferentes patologías.
Habilidades
- HAB01. Saber aplicar el método científico y adquirir habilidades en el manejo de la legislación, fuentes de información, bibliografía, elaboración de protocolos y demás aspectos que se consideran necesarios para el diseño y evaluación critica de ensayos preclínicos y clínicos.
- HAB02. Llevar a cabo las actividades de farmacia clínica y social, siguiendo el ciclo de atención farmacéutica.
- HAB03. Llevar a cabo procesos de laboratorio estándar incluyendo el uso de equipos científicos de síntesis y análisis, instrumentación apropiada incluida.
- HAB04. Estimar los riesgos asociados a la utilización de sustancias químicas y procesos de laboratorio.
- HAB05. Conocer y aplicar las técnicas principales de investigación estructural incluyendo la espectroscopia.
- HAB06. Aplicar los conocimientos de Física y Matemáticas a las ciencias farmacéuticas.
- HAB07. Aplicar técnicas computacionales y de procesamiento de datos, en relación con información referente a datos físicos, químicos y biológicos.
- HAB08. Diseñar experimentos en base a criterios estadísticos.
- HAB09. Evaluar datos científicos relacionados con los medicamentos y productos sanitarios.
- HAB10. Utilizar el análisis estadístico aplicado a las ciencias farmacéuticas.
- HAB11. Desarrollar habilidades relacionadas con el uso de los efectos beneficiosos de las plantas medicinales y comprender los riesgos sanitarios asociados con su mal uso.
- de laboratorios implicados.
- HAB12. Desarrollar habilidades para identificar dianas terapéuticas y de producción biotecnológica de fármacos, así como de uso de la terapia génica.
- HAB13. Evaluar los efectos de sustancias con actividad farmacológica.
- HAB14. Aplicar las técnicas de comunicación oral y escrita adquiriendo habilidades que permitan informar a los usuarios de los establecimientos farmacéuticos en términos inteligibles y adecuados a los diversos niveles culturales y entornos sociales.
- HAB15. Gestionar los medicamentos.
- HAB16. Elaborar fórmulas magistrales y preparados oficinales.
- HAB17. Proporcionar atención farmacéutica a los pacientes.
- HAB18. Realizar farmacovigilancia.
- HAB19. Realizar la facturación de una Oficina de Farmacia, en su caso.
- HAB20. Aplicar las diversas técnicas instrumentales utilizadas en un laboratorio llevando a cabo una correcta interpretación de los resultados
- HAB21. Utilizar las bases de datos y recursos que ofrece la tecnología digital actual
- HAB22. Organizar los datos experimentales y clínicos para su correcto análisis y/o elaboración de informe posterior.
- HAB23. Transmitir ideas, conocimientos, problemas, argumentos y soluciones, tanto de forma oral como escrita a un público especializado o no especializado.
- HAB24. Elaborar y/o redactar informes relacionados con el área de salud.
Competencias
- COMP01. Identificar, diseñar, obtener, analizar, controlar y producir fármacos y medicamentos, así como otros productos y materias primas de interés sanitario de uso humano o veterinario.
- COMP02. Evaluar los efectos terapéuticos y tóxicos de sustancias con actividad farmacológica.
- COMP03. Diseñar, preparar, suministrar y dispensar medicamentos y otros productos de interés sanitario.
- COMP04. Prestar consejo terapéutico en farmacoterapia y dietoterapia, así como en el ámbito nutricional y alimentario en los establecimientos en los que presten servicios.
- COMP05. Promover el uso racional de los medicamentos y productos sanitarios, así como adquirir conocimientos básicos en gestión clínica, economía de la salud y uso eficiente de los recursos sanitarios.
- COMP06. Identificar, evaluar y valorar los problemas relacionados con fármacos y medicamentos, así como participar en las actividades de farmacovigilancia.
- COMP07. Intervenir en las actividades de promoción de la salud, prevención de enfermedad, en el ámbito individual, familiar y comunitario; con una visión integral y multiprofesional del proceso salud-enfermedad.
- COMP08. Diseñar, aplicar y evaluar reactivos, métodos y técnicas analíticas clínicas, conociendo los fundamentos básicos de los análisis clínicos y las características y contenidos de los dictámenes de diagnóstico de laboratorio.
- COMP09. Evaluar los efectos toxicológicos de sustancias y diseñar y aplicar las pruebas y análisis correspondientes.
- COMP10. Desarrollar análisis higiénico-sanitarios, especialmente los relacionados con los alimentos y medioambiente.
- COMP11. Desarrollar habilidades de comunicación e información, tanto orales como escritas, para tratar con pacientes y usuarios del centro donde desempeñe su actividad profesional. Promover las capacidades de trabajo y colaboración en equipos multidisciplinares y las relacionadas con otros profesionales sanitarios.
- COMP12. Reconocer las propias limitaciones y la necesidad de mantener y actualizar la competencia profesional, prestando especial importancia al autoaprendizaje de nuevos conocimientos basándose en la evidencia científica disponible.
- COMP13. Identificar, diseñar, obtener, analizar y producir principios activos, fármacos y otros productos y materiales de interés sanitario.
- COMP14. Seleccionar las técnicas y procedimientos apropiados en el diseño, aplicación y evaluación de reactivos, métodos y técnicas analíticas.
- COMP15. Estimar los riesgos biológicos asociados a la utilización de sustancias y procesos
- COMP16. Diseñar, optimizar y elaborar las formas farmacéuticas garantizando su calidad, incluyendo la formulación y control de calidad de medicamentos, el desarrollo de fórmulas magistrales y preparados oficiales.
- COMP17. Aplicar el control de calidad de productos sanitarios, dermofarmacéuticos y cosméticos y materiales de acondicionamiento.
- COMP18. Programar y corregir la posología de los medicamentos en base a sus parámetros farmacocinéticos.
- COMP19. Determinación de la biodisponibilidad, evaluación de la bioequivalencia y factores que las condicionan.
- COMP20. Utilizar de forma segura los medicamentos teniendo en cuenta sus propiedades físicas y químicas incluyendo cualquier riesgo asociado a su uso.
- COMP21. Desarrollar análisis higiénico-sanitarios (bioquímico, bromatológico, microbiológicos, parasitológicos) relacionados con la salud en general y con los alimentos y medio ambiente en particular.
- COMP22. Promover el uso racional del medicamento y productos sanitarios.
- COMP23. Adquirir las habilidades necesarias para poder prestar consejo terapéutico en farmacoterapia y dietoterapia, así como consejo nutricional y alimentario a los usuarios de los establecimientos en los que presten servicio.
- COMP24. Conocer los fundamentos de la salud pública e intervenir en las actividades de promoción de la salud, prevención de la enfermedad en los ámbitos individual y colectivo y contribuir a la educación sanitaria, reconociendo los determinantes de salud en la población, tanto los genéticos como los dependientes del sexo y estilo de vida, demográficos, ambientales, sociales, económicos, psicológicos y culturales.
- COMP25. Conocer, comprender y aplicar las condiciones legales, sociales y económicas relacionadas con el ámbito sanitario y en particular con el medicamento.
- COMP26. Conocer los principios éticos y deontológicos y actuar según las disposiciones legislativas, reglamentarias y administrativas que rigen el ejercicio profesional colaborando con otros profesionales de la salud y adquiriendo habilidades de trabajo en equipo.
- COMP27. Dominar técnicas de recuperación de información relativas a fuentes de información primarias y secundarias (incluyendo bases de datos con el uso de ordenador).
- COMP28. Conocer y aplicar técnicas de gestión en todos los aspectos de las actividades farmacéuticas.
- COMP29. Organizar y gestionar el funcionamiento de una oficina de farmacia.
- COMP30. Conservación, custodia, dispensación y distribución racional de los medicamentos y otros productos farmacéuticos.
- COMP31. Presentar y defender ante un tribunal un proyecto de fin de grado consistente en un ejercicio de integración de los contenidos formativos recibidos, y las competencias adquiridas.
- COMP32. Trabajar de manera fluida en grupos de trabajo reducidos, entornos multiplataforma y multidisciplinares para la consecución de un objetivo común y respetando los principios básicos de la ética.
Empleabilidad
El 75% de nuestros egresados consigue su primer trabajo en menos de 3 meses y el 100% está trabajando como farmacéutico/a (Datos encuesta empleabilidad 2023-2024)
Salidas profesionales del Grado de Farmacia
Tras cursar la carrera en Farmacia, llega el momento de incorporarse al mundo laboral. Estarás cualificado para trabajar en las principales áreas de actividad relacionadas con productos farmacéuticos: investigación y desarrollo, producción y control de calidad, comercialización, atención y gestión farmacéutica.
Ámbito sanitario
- Titular, adjunto, regente o sustituto en oficina de farmacia comunitaria.
- Diseño, producción y dispensación de fármacos, medicamentos y otros productos de interés sanitario (oficina de farmacia comunitaria y farmacia hospitalaria).
- Elaboración de protocolos y diseño de ensayos preclínicos y clínicos en empresas (CRO).
- Participación en actividades de farmacovigilancia en instituciones públicas o privadas.
- Implementación de actividades de farmacia clínica y social en instituciones sanitarias.
- Programas de promoción de la salud y prevención de la enfermedad (ámbito individual, familiar y comunitario).
- Desarrollo de análisis higiénico-sanitarios relacionados con alimentos y medioambiente.
- Acceso a la especialidad sanitaria a través del FIR.
- Laboratorio clínico: análisis clínicos, bioquímica, parasitología, microbiología y genética.
Administración pública
- Instituciones hospitalarias y de atención primaria.
- Técnico del Ministerio de Sanidad, AEMPS o AECOSAN.
- Inspector y/o técnico de salud pública (instituciones militares o penitenciarias, aduanas, laboratorios municipales, etc.).
Industria farmacéutica
- Control de calidad de medicamentos.
- Diseño racional de fármacos.
- Director técnico de planta de producción farmacéutica.
- Programas regulatorios y monitorización de ensayos clínicos.
- Product manager y dirección técnica de marketing y gestión comercial.
- Medical Scientific Liaison.
- Técnico de la industria cosmética.
- Dirección técnica de almacenes de distribución de medicamentos.
- Dermofarmacia y ortopedia.
- Programas de asesoría, consultoría y diseño de proyectos de I+D+i.
Agroalimentario y ganadero
- Control de calidad y seguridad de los alimentos.
- Farmacéutico en empresas comerciales, veterinarias y agrupaciones ganaderas.
Docente e investigador (Centros públicos y/o privados)
- Docente universitario.
- Personal investigador.
- Intervención en medios de comunicación especializados.
Perfil de egreso
Los graduados en Farmacia podrán realizar actividades dirigidas a la producción, conservación y dispensación de medicamentos, colaborar en procesos analíticos y asistenciales, participar en investigación y docencia, así como en la vigilancia de la salud pública (Ley 44/2003).
Entre las salidas profesionales más destacadas, se encuentran:
- Farmacia hospitalaria
- Oficina de farmacia
- Distribución farmacéutica
- Industria farmacéutica
- Industria alimentaria
- Sanidad ambiental
- Análisis clínicos
- Salud pública
- Administración pública
- Investigación
- Docencia
Acceso A Profesión Regulada
El Grado en Farmacia habilita para el ejercicio de la profesión de farmacéutico/a.
Referencias legales
Resolución de 14 de febrero de 2008, BOE 27 de febrero de 2008
Norma Orden CIN/2137/2008, de 3 de julio, BOE 19 de julio de 2008
El 75 % de nuestros egresados consigue su primer empleo en menos de tres meses, y el 100 % trabaja como farmacéutico/a (datos de la encuesta de empleabilidad 2023-2024).
Admisiones
Comienza tu futuro en Universidad Europea
Sabemos que elegir qué estudiar es una de las decisiones más importantes de tu vida. Por ello, tienes a tu disposición un equipo asesor que te ayudará en todo el camino.
En 3 pasos puedes convertirte en un alumno de Universidad Europea.
1
Pruebas de acceso
Inicia tu proceso llamando a 918257503 o solicita información y nuestros asesores se pondrán en contacto contigo.
2
Reserva de plaza
Una vez admitido podrás abonar tu reserva de plaza para garantizarla.
3
Matrícula
Entrega la documentación necesaria para formalizar tu matrícula.
Programa de becas y ayudas
Queremos ayudarte con una amplia selección de becas propias y oficiales para que te conviertas en estudiante de Universidad Europea.
Convalidaciones y traslados de centro
No tienes por qué seguir en algo que no te gusta. Por eso hemos diseñado planes específicos de convalidaciones y traslados de centro.
Solicita tu estudio de convalidaciones online para cambiar tu expediente y comenzar tus estudios en Universidad Europea.
Perfil de nuevo ingreso y vías de acceso al título
- Calificación de apto en la Prueba para el Acceso a la Universidad,
- Calificación de apto en las Pruebas de Acceso para mayores de 25 años y mayores de 45 años.
- Técnicos de grado Superior.
- Titulados Universitarios.
- Alumnos de Bachillerato de sistemas educativos de Estados miembros de la UE y de otros países con acuerdos internacionales, según lo previsto en la normativa vigente (RD 1892/2008).
- Estudiantes de otros países con estudios homologados y/o prueba/s de acceso a la universidad si así fuera exigible (RD 412/2014).
- Personas mayores de 40 años con experiencia laboral y profesional en el campo sanitario.
Requisitos de acceso
El ingreso en la Universidad Europea de Madrid dependerá de las plazas ofertadas y disponibles en la titulación, y del cumplimiento de los requisitos legales de acceso a la Universidad que contempla la legislación vigente.
Jornada de Puertas Abiertas
Participa en nuestros Open Days para conocer de primera mano nuestro avanzado Modelo Académico de Aprendizaje, al equipo docente que ya piensa en tu futuro, los distintos programas de formación que ponemos a tu disposición y como comenzarás tus estudios este próximo curso académico.
27 junio
Claustro
Más del 85% de nuestros profesores tiene el grado de Doctor en diferentes áreas de conocimiento y muchos de ellos son profesionales que compaginan la actividad docente con la actividad profesional, acercándote a la realidad de la profesión.
Nuestro claustro
- Beatriz Sáez Pizarro
Profesor del Departamento de Ciencias de la Salud de la Facultad de Ciencias Biomédicas de la Universidad Europea de Madrid. Doctor en Farmacia y Licenciado en farmacia por la UCM. Máster en Administración y Dirección de Empresas por ICADE, Máster en Marketing Farmacéutico por el Instituto de Empresa y Curso Superior en Gestión de Oficina de Farmacia por el Centro de Estudios Financieros. Ha realizado estancia internacional en el Institut Nacional de la Recherche Agronomique (I.N.R.A.) Francia, Clermont-Ferrand y ha sido admitido también en University College London, Department of Biochemistry and Molecular Biology; King’s College London, University of London, Department of Nutrition and Dietetics; University of Nottingham, Faculty of Medicine, Department of Physiology and Pharmacology. Ha participado en numerosos proyectos en la oficina central de Janssen Pharmaceutica en Bélgica. Aparte de su experiencia como docente, tanto de clases teóricas como prácticas en grado y postgrado, tiene experiencia en la industria farmacéutica en diversas posiciones relacionadas con el Marketing Farmacéutico y la Gestión Territorial, como visitador médico en Janssen-Cilag, del Grupo Johnson & Johnson, como Inspector Farmacéutico Municipal y como Titular de Oficina de Farmacia. Es el Directora Académico del Curso de Expertos en Gestión de Oficina de Farmacia. - Beatriz Chacón Ovejero
La profesora Beatriz Chacón Ovejero es Licenciada en Farmacia por la Universidad Complutense de Madrid. Ha realizado formación complementaria con un Curso de Clinical Trials Assistant (CTA), así como numerosos cursos de formación continuada y actualmente cursa el Doctorado en Oncología en la Facultad de Ciencias Biomédicas y de la Salud de la Universidad Europea de Madrid.
Posee más de veinte años de experiencia profesional en el área de oficina de farmacia, habiendo desarrollado su labor asistencial y de gestión en el ámbito comunitario, así como 4 años de experiencia docente universitaria en la Universidad Europea de Madrid.
En cuanto a su actividad investigadora, colabora en la línea de oncología traslacional y farmacogenómica, siendo coautora del artículo indexado Metabolic mechanisms of immunotherapy resistance publicado en Exploration of Targeted Anti-tumor Therapy (2025). Asimismo, ha dirigido dos Trabajos Fin de Máster y continúa desarrollando su investigación doctoral en el área oncológica.
Tiene amplia experiencia docente en asignaturas como Farmacocinética, Análisis Biológicos y Diagnóstico de Laboratorio, Procesos Biológicos II, Farmacología y Farmacogenética y Farmacogenómica, impartidas en los Grados de Farmacia y Enfermería de la Universidad Europea de Madrid. Además, imparte docencia en el Máster en Industria Farmacéutica y Biotecnología: Terapias Avanzadas, Producto Sanitario y Biológicos y en el Posgrado de Enfermería en Dermoestética. - Sonia Moreno Pérez
Profesora Titular en Enzimología del departamento de Ciencias de la Salud de la Facultad de Ciencias Biomédicas de la Universidad Europea de Madrid (UEM). Licenciada es Biología, especialidad Biosanitaria, por la Universidad Complutense de Madrid. Doctora en Ciencias Biomédicas con una calificación de “Sobresaliente Cum Laude” por la Universidad Autónoma de Madrid (UAM). Máster Oficial en Biotecnología, Especialidad Biotecnología Industrial y Nanobiotecnología, por la UAM. Acreditada como profesor contratado doctor, profesor ayudante doctor y profesor de universidad privada por la ANECA. Tiene una amplia experiencia como docente en diferentes grados: Biotecnología (español y 100% inglés), Farmacia, Odontología 100% inglés y Nutrición Humana y Dietética Online. Experiencia investigadora en áreas de Ingeniería Enzimática. Cuenta con más de 25 publicaciones en revistas indexadas JCR, ha dirigido una Tesis Doctoral y varios trabajos finales de Máster y Grado, además de una patente publicada. Desde el 2019, es directora interna y coordinadora de autoría del Máster Online en Microbiota, Probióticos y Prebióticos. También es de destacar premio a la enseñanza y aprendizaje digital en las XIV jornadas de innovación universitaria de la UEM. - Elena Pérez Izquierdo
Profesora titular en Tecnología Farmacéutica del Departamento de Ciencias de la Salud de la Facultad de Ciencias Biomédicas de la Universidad Europea de Madrid. Licenciada en Biología por la Universidad Complutense de Madrid. Máster en Ciencias Farmacéuticas en la Facultad de Farmacia (UCM). Acreditada como profesor contratado doctor, profesor ayudante doctor y profesor de universidad privada. Experiencia docente universitaria de 10 años. Doctora en Ciencias Biomédicas por la Universidad Complutense de Madrid, Departamento de Bioquímica y Biología Molecular III de la Facultad de Medicina. Colaboradora honorífica del Dpto. Bioquímica y Biología Molecular (UCM) para la docencia práctica de asignaturas relacionadas con dicho departamento en los grados de Medicina, Odontología y Nutrición. Ha realizado estancias científicas en el centro de investigación International Iberian Nanotechnolog y Laboratory, Braga (Portugal) y en el centro de investigación IDIBAPS (Barcelona). Es autora de más de 10 publicaciones en forma de artículos en revistas científicas especializadas y ha participado de forma activa en más de 6 proyectos de investigación. Actualmente forma parte del grupo de investigación de Biotecnología Aplicada de la Universidad Europea de Madrid, desarrollando varias líneas de investigación basadas en el uso de nanopartículas para el tratamiento del cáncer. - Ana María Fernández Olleros
Profesora del departamento de Ciencias de la Salud de la Facultad de Ciencias Biomédicas. Doctora en Farmacia con premio extraordinario de doctorado por la Universidad Complutense de Madrid, Master en Ciencias Farmacéuticas y Licenciada en Farmacia por la Universidad Complutens de Madrid. Ha realizado varias estancias científicas en el Departamento of Chemical Engineering, University of Texas en Austin (Estados Unidos) y en el Grupo de Investigación Nuevos Materiales y Espectroscopia Supramolecular Departamento Química Física, Facultad Ciencia y Tecnología, Universidad del País Vasco. Es Instructora en Simulación Clínica por Institute for Medical Simulation y Hospital Virtual Valdecilla. Cuenta con más de 7 artículos científicos en revistas indexadas, es co-autora de varios capítulos de libro y en numerosas publicaciones a congresos científicos. Ha participado en más de 10 proyectos de investigación. Es co-autora del Libro Blanco de Prácticas Tuteladas en el Grado de Farmacia y co-fundadora del grupo de investigación de Simulación en ciencias de la salud. Cuenta con una elevada experiencia como docente tanto en títulos presenciales con no presenciales y en postgrado. - Iván Fernández de Lamo
Profesor del departamento de Ciencias de la Salud en la facultad de Ciencias Biomédicas de la Universidad Europea de Madrid. Licenciado en Bioquímica por la Universidad Autónoma de Madrid. Doctor en Bioquímica, Biología Molecular y Biomedicina por la Universidad Autónoma de Madrid. Especialista en Neurofisiología con 3 periodos posdoctorales en la División de Neurociencias de la universidad Pablo de Olavide en Sevilla, bajo la dirección de Prof. José María Delgado Garcia y la Prof. Agnès Gruart. En el departamento de neurociencia del Perelman School of Medicine in the University of Pennsylvania (USA) en el laboratorio del Prof. Diego Contreras, y en el laboratorio de Circuitos Neuronales del Instituto Cajal de Madrid del CSIC bajo la dirección de Liset Menedez de la Prida. Donde ha publicado 12 artículos científicos y dos capítulos de libro. Con 3 años de experiencia docente en el área de la Anatomía y Fisiología del Cuerpo Humano. - Piedad Ros Viñegla
Profesora e investigadora del Departamento de Ciencias de la Salud en la Facultad de Ciencias Biomédicas de la Universidad Europea de Madrid. Licenciada en Químicas por la Facultad de Ciencias de la Universidad de Granada. Doctor en Químicas por la Facultad de Farmacia de la Universidad de Granada. En el campo de investigación, realizó la tesis doctoral en la Facultad de Farmacia de la Universidad de Granada becada por la empresa Boehringer Ingelheim y ha participado en los diversos proyectos de investigación en la Universidad de Granada, la UNED, el Instituto de Investigaciones Biomédicas Alberto Sols-Csic y la Universidad Europea de Madrid (UEM). Su actividad Investigadora se inició en 1998 en el Departamento de Química Física de la Facultad de Farmacia de la Universidad de Granada. Ha participado como investigadora en un proyecto el MINECO y dos proyectos financiados por la UEM y ha colaborado con el Instituto de Investigaciones Biomédicas AlbertoSols-Csic. En el ámbito docente cuenta con una gran experiencia fundamentalmente en el área de Química-Física, y ha trabajado de profesora asociada en el Departamento de Química-Física de Facultad de Químicas de la Universidad de Granada, en el Departamento de Química-Física de la Facultad de Farmacia de la Universidad de Granada, en el Departamento de Química Analítica de la Facultad de Químicas de la Universidad Complutense, Madrid, y en la actualidad en la Universidad Europea de Madrid, así como en varios centros privados desde 1996. Ha impartido clases en las titulaciones de Ciencias Químicas, Ciencias Medioambientales, Ingeniería Aeroespacial, Farmacia y Biotecnología, en las asignaturas tales como Fisicoquímica, Química, Análisis Químico, Termodinámica y Cinética, Estadística, Farmacocinética, Macromoléculas y Electroquímica. - Manuel Pizarro Sánchez
Profesor del Departamento de Ciencias de la Salud de la Facultad de Ciencias Biomédicas de la Universidad Europea de Madrid. Doctor en Farmacia y Licenciado en farmacia por la UCM. Máster en Administración y Dirección de Empresas por ICADE, Máster en Marketing Farmacéutico por el Instituto de Empresa y Curso Superior en Gestión de Oficina de Farmacia por el Centro de Estudios Financieros. Ha realizado estancia internacional en el Institut Nacional de la Recherche Agronomique (I.N.R.A.) Francia, Clermont-Ferrand y ha sido admitido también en University College London, Department of Biochemistry and Molecular Biology; King’s College London, University of London, Department of Nutrition and Dietetics; University of Nottingham, Faculty of Medicine, Department of Physiology and Pharmacology. Ha participado en numerosos proyectos en la oficina central de Janssen Pharmaceutica en Bélgica. Aparte de su experiencia como docente, tanto de clases teóricas como prácticas en grado y postgrado, tiene experiencia en la industria farmacéutica en diversas posiciones relacionadas con el Marketing Farmacéutico y la Gestión Territorial, como visitador médico en Janssen-Cilag, del Grupo Johnson & Johnson, como Inspector Farmacéutico Municipal y como Titular de Oficina de Farmacia. Es el Director Académico del Curso de Expertos en Gestión de Oficina de Farmacia. - Francisco José Farfán Sedano
Profesor del departamento de Ciencias de la Salud de la Facultad de Ciencias Biomédicas de la Universidad Europea de Madrid. Licenciado en Farmacia por la Universidad Complutense de Madrid. Farmacéutico Especialista en Farmacia Hospitalaria, personal estatutario fijo en la Comunidad de Madrid, con más de 10 años de experiencia como Jefe de Servicio de Farmacia del Hospital Universitario de Fuenlabrada. Realizó su residencia en el Servicio de Farmacia del Hospital Universitario de Getafe, donde estuvo más de 4 años después como responsable del Área de Información y Evaluación de Medicamentos. Es Diplomado en Sanidad por la Escuela Nacional de Sanidad, posee diferentes Máster en el campo de la Gestión Estratégica, Administración y Dirección de Servicios Sanitarios y de Farmacia y Tecnología de Medicamentos. Vocal del Comité de Continuidad Asistencial Grupo de Trabajo de recomendaciones Farmacoterapéuticas de la Consejería de Sanidad de la Comunidad de Madrid durante 4 años. Miembro y vicepresidente de la Fundación Pharmaceutical Care España. Farmacéutico Comunitario en la Comunidad de Madrid y forma parte de algún grupo de trabajo de FORO-Atención Farmacéutica del Consejo General de Colegios Oficiales Farmacéuticos.
Autor de numerosas comunicaciones en congresos nacionales e internacionales, así como ponente en numerosos cursos de formación para farmacéuticos, nacionales e internacionales, profesor en el MBA en Empresas Farmacéuticas y Biotecnológicas de EPHOS, también ha dirigido cursos relacionados con la selección y evaluación de medicamentos en hospitales.
Ha realizado estancias en los Servicios de Farmacia Medicina Interna y Farmacocinética Clínica en el Los Angeles County Hospital de la Universidad de California, U.S.A
Principales líneas de investigación en torno a la Atención Farmacéutica, implantación de Servicios Profesionales: la Conciliación de Medicamento en las transiciones asistenciales, cómo director del proyecto según convenio por el Ministerio de Sanidad y Consumo (BOE 12/01/2009).
Miembro de la Sociedad Española de Farmacia Hospitalaria, de la Sociedad Española de Farmacia Clínica, Familiar y Comunitaria, de la American Society of Health-System Pharmacist y de la FIP, con participación algunos de los grupos de trabajo de dichas agrupaciones farmacéuticas profesionales. - Clara Colina
La profesora Clara Colina Coca es Diplomada en Nutrición Humana y Dietética por la Universitat de Vic, licenciada en Ciencia y Tecnología de los Alimentos por la Universitat de Vic, Máster en Calidad y Seguridad Alimentaria: Sistema APPCC por la Universitat de Vic, Máster en Calidad y Seguridad Alimentaria por la Universidad del País Vasco, Doctora en Nutrición por la Universidad Complutense de Madrid, Posgrado en Nutrición Deportiva por el Comité Olímpico Internacional, Posgrado en Nutrición Genómica y de precisión por Tech Universidad Tecnológica, y Máster en Nutrición Deportiva por la Universitat de Valencia. Posee experiencia profesional en el área de calidad y seguridad alimentaria habiendo trabajado en empresas como APPlus y los Laboratorios Altimir. Además, también posee experiencia como nutricionista con especialidad en educación nutricional, nutrición deportiva y recomposición corporal tanto por cuenta propia como por cuenta ajena habiendo trabajado en centros como O2 Wellness, y en el Centro integral de salud y rendimiento I-Shape de la Universidad Europea de Madrid.
En cuanto a su actividad investigadora, ha trabajado en la línea de Calidad y funcionalidad de alimentos vegetales en el Instituto de Ciencia y Tecnología de los Alimentos y Nutrición (CSIC-ICTAN), participando en dos proyectos competitivos, con 9 artículos publicados en revistas indexadas, 5 publicaciones No-SCI, 6 presentaciones a congresos, así como la publicación de un capítulo de libro.
Tiene experiencia docente en asignaturas como Nutrición Básica, Bromatología, Ciencia y Tecnología de los Alimentos, Toxicología y Nutrición en el deporte impartidas en Grado, y en asignaturas como Nutrición en lesiones deportivas y Antropometría avanzada en Máster, con más de 7 años de experiencia universitaria. Además, ha dirigido TFGs y TFMs, ha elaborado materiales docentes para universidades como FUNIBER, Tech Universidad Tecnológica y la Universidad Europea de Madrid, y ha participado en comités académicos y científicos. - Claudia Owsianik
Graduada en Farmacia y en el máster en biología vegetal aplicada por la Universidad. Complutense de Madrid. Actualmente realizando la tesis doctoral en el departamento de Farmacología, Farmacognosia y Botánica. Formación en investigación y en el ámbito profesional en los productos naturales y en el uso del medicamento. Esta formación multidisciplinar repercute positivamente en mi destreza en el ámbito de la investigación. Mi experiencia investigadora se centra en el entorno de la Farmacología de productos naturales o farmacognosia y consta de una publicación en revista con un alto índice de impacto e indexada en JCR (Q1). He participado en 14 cursos de formación algunos de ellos de carácter internacional.
Participo activamente como equipo de trabajo en el proyecto de investigación con número de referencia PID2023-147388NB-I00 del Plan Nacional, Ministerio de Ciencia e Innovación basado en el estudio de la filogenia de especies y la diversidad química en organismos simbióticos. Mi aportación a este proyecto de centra en la aplicación de las técnicas de DNA barcoding y caracterización de extractos liquénicos por métodos como HPLC, así como su estudio a nivel de capacidad biológica. Experiencia laboral. Farmacéutica adjunta (2020-Actualidad) responsable de dispensación de medicamentos y atención farmacéutica al paciente. Manejo de diferentes programas informáticos como Farmatic, recepción de pedidos, gestión de stocks, control de caducidades, elaboración y dispensación de fórmulas magistrales, gestión del libro recetario electrónico, dispensación de psicótropos y estupefacientes, así como su correspondiente control en el libro de estupefacientes. - Emilia Elena Diaz López
La profesora Emilia Elena Díaz López es farmacéutica, por la Universidad Central de Venezuela (UCV) (homologado al correspondiente título español de Licenciada) y Doctora en Ciencias Mención Farmacología por UCV (homologado al correspondiente título español de Doctora en Farmacia). Posee experiencia profesional en el área de la oficina de farmacia y visita médica en laboratorios Pfizer. En cuanto a su actividad investigadora, ha trabajado en la línea del papel de la adrenomedulina cerebral en la función cardiovascular y renal en el Instituto de Investigaciones Farmacéuticas (UCV) participando en tres proyectos competitivos, con ocho artículos publicados en revistas indexada. Además, ha trabajado en la línea de investigación sobre el papel de los neuropéptidos en la relación parásito hospedero, en el Instituto de Medicina Experimental, UCV, participando en dos proyectos, con seis artículos científicos y dos capítulos de libros. Ha realizado una estancia científica en el Hospital Douglas Research en Montreal, Canadá. Tiene experiencia docente en asignaturas como Fisiología, Fisiopatología, Toxicología y Estructura y función, impartidas en el grado de Nutrición y Dietética Humana, Farmacia, Biomedicina, Ingeniería Biomédica y en el Master de Toxicología y el Doctorado de Farmacología (UCV), con más veinticinco años de experiencia universitaria. Además, TFM, participado en comités académicos y congresos, y ha recibido premios o reconocimientos académicos. - Héctor García Cabrera
El profesor/a Héctor García Cabrera es Graduado en Física por la Universidad de La Laguna, Máster en Física Avanzada por la Universitat de València y Doctor en Física Experimental de Altas energías por la Universidad Autónoma de Madrid. En cuanto a su actividad investigadora, ha trabajado en la línea de Física Experimental de Altas Energías en el centro de investigación CIEMAT, participando en varios proyectos competitivos, con 3 artículos publicados. Ha realizado estancias científicas en múltiples instituciones como CERN, DESY, IPNL Lyon, LAL e IFIC. Tiene experiencia docente en asignaturas como Biofísica, Matemáticas y Técnicas Instrumentales, impartidas en los grados de Farmacia y Biotecnología, con 2 años de experiencia universitaria. Además, ha participado en numerosos congresos internacionales como LCWS23 - Iris Azami Conesa
La profesora Iris Azami Conesa es Licenciada en Biología por la Universidad Complutense de Madrid, con especialidad en zoología, Máster en Enfermedades Parasitarias Tropicales por la Universidad de Valencia y Doctora en Veterinaria por la Universidad Complutense de Madrid. Posee experiencia profesional en el área de la sanidad animal y la divulgación científica, habiendo trabajado en empresas como Lokimica S.A y el Museo de Ciencias y Tecnología de Madrid. En cuanto a su actividad investigadora, ha trabajado en líneas de investigación sobre parasitología humana y animal, recuperación y reintroducción de fauna silvestre y en el estudio de resistencias a antiparasitarios en la Universidad Complutense de Madrid, en colaboración con la Universidad Autónoma de Madrid, la Universidad CEU Cardenal Herrera, la Universidad Católica de Valencia y GREFA, así como con numerosos centros de recuperación de fauna de diversas provincias de España. También ha participado en proyectos de investigación de fauna silvestre en Argentina, en la Universidad de la Patagonia Austral y en Costa Rica en colaboración con ASVO. Ha participado en 4 proyectos competitivos, y actualmente cuenta con 10 artículos publicados en revistas indexadas de primer y segundo cuartil, cuyo número sigue creciendo por el continuado trabajo en investigación que realiza. Ha realizado estancias científicas en la Universidad de la Sapienza de Roma (Italia). Tiene experiencia docente en asignaturas como Parasitología y Microbiología impartidas en los Grados en Farmacia, Nutrición humana y dietética, Odontología y Veterinaria, así como en el Master de Biotecnología Clínica. Imparte docencia en español e inglés desde varios años y cuenta con más de 5 años de experiencia universitaria. Además, ha participado en numerosos congresos internacionales de parasitología en los últimos 10 años, donde ha presentado comunicaciones orales y trabajos de gran relevancia en el área. - Jesús Pacheco Torres
El profesor Jesús Pacheco Torres es Licenciado en Química por la Universidad de Jaén y Doctor en Bioquímica por la Universidad Autónoma de Madrid. Actualmente es Científico Titular en el Instituto de Investigaciones Biomédicas Sols-Morreale (CSIC), donde dirige su propio grupo de investigación. Ha desarrollado una amplia trayectoria en el ámbito de la imagen biomédica, con estancias y posiciones en instituciones de referencia como la Johns Hopkins University School of Medicine (EE. UU.) y el Instituto de Neurociencias (CSIC, España). Cuenta con dos sexenios de investigación reconocidos por la CNEAI y fue beneficiario de una prestigiosa beca Marie Skłodowska-Curie. Su actividad investigadora se centra en la interacción entre el metabolismo tumoral, los puntos de control inmunitarios y el microambiente tumoral, con especial énfasis en el glioblastoma. Es investigador principal de proyectos nacionales e internacionales y autor de más de 40 publicaciones indexadas, un capítulo de libro y una patente. Ha realizado estancias científicas en centros internacionales de prestigio en Estados Unidos y Reino Unido. En el ámbito docente, ha impartido clases en la Universidad Europea de Madrid y en programas de formación especializada del CSIC, además de dirigir trabajos de fin de grado y máster y co-dirigir tesis doctorales. - Laura Pérez Blázquez
La profesora Laura Pérez Blázquez es Graduada en Farmacia por la Universidad de Salamanca, Máster en Investigación Clínica y Medicina Farmacéutica por EPHOS, y doctoranda en ciencias biomédicas y salud pública por la UNED. Posee experiencia profesional en el área de farmacología, habiendo trabajado en empresas como MSD, o farmacia comunitaria. En cuanto a su actividad investigadora, ha trabajado en la línea de inmunopatología del VIH en el instituto de investigación Carlos III, participando en proyectos competitivos. Ha realizado estancias científicas en la Universidad de Singapur. Tiene experiencia docente en asignaturas como farmacología, farmacocinética o inmunología, impartidas en diferentes grados como medicina, farmacia, biotecnología u odontología, con más de 4 años de experiencia universitaria. Además, ha dirigido TFGs, tanto bibliográficos como experimentales, y participado en varios congresos a nivel nacional e internacional. - José Miguel Pérez Moreno
Doctorando en Química Médica, graduado en farmacia con experiencia docente en Química Orgánica y Química Farmacéutica. Especializado en síntesis estereoselectiva de agentes terapéuticos, con participación activa en investigación científica, tutoría de TFMs y formación de grado. - Laura Redondo
Profesora del departamento de Ciencias de la Salud de la Facultad de Ciencias Biomédicas. Doctora en Biomedicina y Ciencias de la Salud por la Universidad Europea de Madrid y Graduada en Farmacia por la Universidad Complutense de Madrid. Asimismo, está acreditada por la ANECA en las figuras de Profesor Ayudante Doctor, Profesor Contratado Doctor y Profesor Universidad Privada en el área de Ciencias de la Salud. Asimismo, también cuenta con un sexenio de investigación. Su experiencia profesional se encuentra en el área de la Farmacología, habiendo trabajado como Farmacéutica Adjunta en Farmacia Comunitaria durante más de 7 años.
Es autora de veintitrés publicaciones en revistas indexadas relacionadas con el análisis de la respuesta psicofisiológica al estrés en estudiantes y docentes en entornos académicos, así como con distintos aspectos relacionados con la Salud. También es autora de un capítulo de libro y posee participaciones en Congresos relacionados con la docencia.
Posee más de 4 años de experiencia docente, impartiendo clase en los grados de Enfermería, Odontología, Biomedicina, Biotecnología, Farmacia y Nutrición, además de Tecnología Farmacéutica III y Productos Sanitarios y Dermocosméticos en el grado en Farmacia. También cuenta con experiencia en estudios de posgrado, dirigiendo Trabajos Fin de Máster. - Luisa Andrea Solano
La profesora Luisa Andrea Solano Pérez es Graduada en Nutrición y Dietética por la Universidad Del Bío-Bío. Chile. Graduada en Ciencia y Tecnología de los Alimentos por la Universidad Complutense de Madrid. (título homologado). Magister en Ciencias de la Nutrición con mención Nutrición Clínica del Adulto por Universidad de Chile. Máster en Gestión e Innovación Gastronómica y Ciencias de la Alimentación por la Universidad Camilo José Cela. Doctora en Nutrición por Universidad Complutense de Madrid. Cum Lauder. Posee experiencia profesional en el área de docencia universitaria, gestión clínica, restauración colectiva y gastronomía habiendo trabajado en empresas como Universidad Andrés Bello, Clínica Alemana y Clínica Los Coihues en Santiago de Chile
En cuanto a su actividad investigadora, ha trabajado en la línea de enfermedades neurológicas y trastornos en el proceso deglutorio en el centro de investigación Centro de Referencia Estatal de Atención al Daño Cerebral (Ceadac) del Imserso en Madrid, con 3 artículos publicados en revistas indexadas y 4 capítulos de libros.
Tiene experiencia docente en asignaturas como Dietoterapia y Nutrición clínica y dietética hospitalaria, tecnología de los alimentos, planificación de menús y técnicas culinarias especiales, tecnología Culinaria y cocina, alergias e intolerancia alimentarias en Grado Nutrición Humana y Dietética. En el grado de Farmacia las asignaturas tecnología de los alimentos y legislación, Nutrición básica. En el área de posgrado, en el Máster Universitario en Nutrición Clínica: módulo 7 enfermedades neurológicas y renales y Trabajos Fin de máster. Máster Universitario en Nutrición, Composición Corporal y Metabolismo. Módulo 6. Nutrición y metabolismo en la salud hormonal. Nutrición en la fertilidad y en el ciclo de la mujer.
Con más de 10 años de experiencia universitaria. Además, ha dirigido TFM, participado en congresos nacionales e internacionales. Actualmente participa en los siguientes comités académicos y científicos: Miembro de la sociedad española de nutrición clínica y metabolismo (SENPE), Miembro del comité académico del proyecto Upcycling para un Futuro Sostenible en la Universidad del Desarrollo. Santiago. Chile, Miembro de la Asociación Internacional para la Protección del Patrimonio Gastronómico y Miembro del comité científico para la actualización de las Guías Alimentarias para Chile. Universidad de Chile. Instituto de Nutrición y Tecnología de los alimentos. - María Teresa Coiras
La profesora María Teresa Coiras López es Licenciada en Farmacia por la Universidad Complutense de Madrid, Doctora en Farmacia (Inmunología y Microbiología) por la Universidad Complutense de Madrid y catedrática de Inmunología de la Universidad Europea de Madrid. Está acreditada por ANECA como Profesor Ayudante Doctor, Profesor de Universidad Privada y Profesor Contratado Doctor (2019) y cuenta con reconocimiento de tres sexenios de investigación (1998–2007, 2008–2013 y 2014–2019) por la CNEAI. Posee experiencia profesional en el área de investigación biomédica y virología, habiendo desarrollado su carrera en el Instituto de Salud Carlos III (ISCIII) (Centro Nacional de Microbiología, CNM) donde es jefa de la Unidad de Patogenia Inmune y Reservorio Viral. En cuanto a su actividad investigadora, ha trabajado en la línea de patogenia inmune y reservorios virales en la infección por VIH, inmunopatogenia del cáncer y del Long COVID, así como en respuesta a vacunas en pacientes inmunocomprometidos en el Instituto de Salud Carlos III (CNM, ISCIII), dirigiendo 18 proyectos de investigación en concurrencia competitiva como investigadora principal, participando en 27 proyectos competitivos como investigadora colaboradora y en 8 ensayos clínicos, uno de ellos como promotora del ensayo, con 80 artículos publicados en revistas indexadas, 1 patente y 2 modelos de utilidad, además de más de 150 comunicaciones en congresos nacionales e internacionales y participación en la redacción de 9 libros. Ha realizado estancias científicas en el Institut Pasteur (París, Francia, 2011) y tiene experiencia en experimentación animal. Tiene más de 25 años de experiencia docente, ha impartido docencia en 16 asignaturas diferentes correspondientes a 6 grados (Farmacia, Biotecnología, Enfermería, Odontología, Biomedicina y Medicina) en la Universidad Europea de Madrid y la Universidad Complutense de Madrid, así como en 2 másteres universitarios (Máster en Microbiología Aplicada a la Salud Pública e Investigación en Enfermedades Infecciosas, Universidad de Alcalá de Henares, y Máster de Biología Sanitaria, UCM). Su actividad docente abarca teoría y clases prácticas en asignaturas de Inmunología, Biotecnología Farmacéutica, Biotecnología Experimental, Farmacología, Farmacocinética, Microbiología, Virología, Cultivos Celulares e Investigación Biomédica, en más de 20 cursos académicos consecutivos desde 1995 hasta 2025. Además, ha dirigido 7 tesis doctorales, 32 TFM, y TFG, supervisa actualmente 12 tesis doctorales y 2 TFM, ha participado en comités académicos, presidencia y organización de congresos, y ha recibido premios y reconocimientos académicos, entre ellos el Premio a la Mejor Comunicación Oral en la First European Conference on Influenza (2001) y el Premio al Mejor Investigador Joven en 2011 (Ministerio de Sanidad y FIPSE). - Marta Fernández Gómez
La profesora Marta Fernández Gómez es Licenciada en Biología por la Universidad de Extremadura (UEx), Máster en Neurociencias por la Universidad Pablo de Olavide (UPO), y Doctora en Neurociencias por la Universidad del País Vasco/Euskal Herriko Unibertsitatea (UPV/EHU). Posee experiencia profesional en el ámbito de la investigación biomédica, habiendo trabajado en diferentes instituciones españolas y extranjeras. Durante su doctorado en la UPV/EHU, centró su trabajo en el estudio del autismo y las estructuras cerebrales afectadas en este trastorno del neurodesarrollo, mientras que en su etapa postdoctoral en la University of California, Los Ángeles (UCLA), se especializó en el estudio de procesos cognitivos como la toma de decisiones, el papel de la dopamina y las estructuras cerebrales asociadas a dichos procesos.
En cuanto a su actividad investigadora, ha desarrollado su trabajo en la línea de neurociencias, participando en varios proyectos y colaboraciones, con la publicación de 6 artículos en revistas indexadas, capítulos de libros y un total de 10 comunicaciones en congresos científicos. Asimismo, ha realizado estancias de investigación en instituciones de reconocido prestigio internacional, como UCLA (Estados Unidos).
Tiene experiencia docente desde 2024 como profesora en la Universidad Europea de Madrid (UEM), donde imparte asignaturas como Estructura y Función, Ciencias Básicas y Anatomía y Fisiología en los grados de Farmacia, Veterinaria y Odontología, tanto en castellano como en inglés. - Mercedes Alonso Cascón
La profesora Mercedes Alonso Cascón es Licenciada en ciencias Químicas (Bioquímica y Biología molecular) por la Universidad Autónoma de Madrid, y Doctor en Química Orgánica (instituto de Química Médica-CSIC) por la Universidad Autónoma de Madrid. Está acreditada por ANECA como Profesor ayudante doctor, Profesor contratado doctor y Profesor de universidad privada. Posee experiencia profesional en el área de Química Médica, habiendo trabajado en empresas como Noscira S.A como investigador senior. En cuanto a su actividad investigadora, ha trabajado en la línea de búsqueda de nuevos fármacos para diversas enfermedades neurodegenerativas en el Instituto de Química Médica (CSIC), con 15 patentes, 7 artículos publicados en revistas indexadas y 1 capítulo de libro. Además, participa activamente en varios proyectos de innovación docente. Ha realizado estancias científicas en el instituto de química y bioquímica Kekulé, Bonn, Alemania. Tiene experiencia docente en asignaturas como Química General Farmacéutica I y II, Química Orgánica I y II, Técnicas Instrumentales Farmacéuticas y Química Farmacéutica I y II, impartidas en Grado de Farmacia principalmente, con más de 8 años de experiencia universitaria. Además, ha participado en numerosos comités académicos y congresos. - Miguel Muñoz Silva
El profesor Miguel Muñoz Silva es Graduado/Licenciado en Farmacia por la Universidad Complutense de Madrid y Máster en Bioinformática aplicada a la Medicina Personalizada y la Salud impartido por el Instituto de Salud Carlos III (ISCIII) y el Centro Nacional de Investigaciones Oncológicas (CNIO), junto con el Centro Nacional de Supercomputación (BSC-CNS) y la Sociedad Española de Biotecnología (SEBiot).
Posee experiencia profesional no solo en el área asistencial, habiendo trabajado en farmacia comunitaria sino también en el área industrial, como especialista en Control de Calidad en ROVI Laboratorios Farmacéuticos.
En cuanto a su actividad investigadora, ha trabajado en la línea de Química Médica, centrado en el descubrimiento de nuevos fármacos para enfermedades neurodegenerativas en el grupo BIOHet, situado en la Facultad de Farmacia de la Universidad Complutense de Madrid, participando en dos proyectos competitivos y en tres proyectos de innovación docente. Actualmente, en la Universidad Europea de Madrid, sus investigaciones se centran en el estudio de nanomateriales basados en grafeno, su posible relación y aplicación en el envejecimiento celular.
Tiene experiencia docente en asignaturas como Farmacología, impartida en los Grados en Farmacia, Enfermería, Medicina, Biotecnología, Biomedicina, Odontología y Química Farmacéutica en el Grado de Farmacia, con más de cinco años de experiencia universitaria. Además, ha dirigido TFG y TFM, participando en comités académicos y congresos nacionales e internacionales, tanto como organizador como participante con comunicaciones orales y/o posters. - Mónica Manzano Mosteiro
La profesora Mónica Manzano Mosteiro, es Licenciada en Farmacia (UCM), Licenciada en Ciencia y Tecnología de los Alimentos (UCM) y Graduada en Nutrición Humana y Dietética (UAX), Máster en Nutrición (UCM) y Doctora en Farmacia en el Área de Nutrición clínica y Ciencias Biomédicas [UCM]. Posee experiencia profesional en nutrición clínica con consulta privada y con estancia asistencial en el Departamento de enfermedades infecciosas en el Hospital Ramón y Cajal y colaboradora con la asociación de celiacos CELICALIA. En cuanto a su actividad investigadora, ha trabajado como investigadora colaboradora en la línea del estudio de la dieta y su relación con la microbiota, la respuesta inmune y la infección dentro del Área de Microbiología, Inmunología e Infección en el Instituto Ramón y Cajal de Investigación Sanitaria (IRYCIS) y en el Instituto de Investigación Biomédica del Hospital Clínico San Carlos (IdISSC), participando en 3 proyectos competitivos, con varias revistas indexadas y 1 capítulo de libro. Tiene experiencia docente en asignaturas como Dietoterapia, Dietética, Farmacología aplicada a la nutrición, Nutrición Básica II, Restauración Colectiva, impartidas en el Grado de Nutrición Humana y Dietética. En el ámbito de posgrado, ha participado como docente en los módulos de Método Científico y Gestión de la Información, así como en Enfermedades Neurológicas, dentro del Máster de Nutrición Clínica. Asímismo, imparte docencia en el módulo de Alergias e Intolerancias Alimentarias del Máster de Nutrición en la Infancia y Adolescencia. A lo largo de su trayectoria, ha dirigido más de 15 Trabajos Fin de Máster. - Natalia Girón Calvo
El profesor/a Natalia Girón Calvo es Licenciado en Farmacia por la Universidad Complutense de Madrid y Doctor en Farmacia por la Universidad Complutense de Madrid. Está acreditado por ANECA como Profesor Ayudante Doctor, Contratado Doctor y Profesor de Universidad Privada. Posee experiencia profesional en el área de Farmacología, habiendo trabajado en empresas como Novartis, Pfizer o Teva. En cuanto a su actividad investigadora, ha trabajado en las líneas (1) aislamiento y estudio de la actividad farmacológica de productos de origen natural: mecanismos bioquímicos y farmacológicos, (2) diseño de nuevos sistemas de uso oftálmico, tópico o intraocular, que incluyan nuevas sustancias activas y biomateriales e (3) inmunomodulación en la Universidad Complutense de Madrid y Universidad Europea de Madrid, participando en 7 proyectos competitivos, con 8 artículos publicados en revistas indexadas. Tiene experiencia docente en asignaturas como Farmacología, Epidemiología y Salud Pública impartidas en el Grado en Farmacia, Odontología y Enfermería con más de 7 años de experiencia universitaria. Además, ha participado en más de 16 congresos nacionales e internacionales. - Prudencio Sáez Martínez
El profesor Prudencio Sáez Martínez es Graduado en Biología, Máster en Investigación Biomédica Traslacional, y Doctor en Biomedicina por la Universidad de Córdoba (UCO). Está acreditado por ANECA como profesor contratado doctor. En cuanto a su actividad investigadora, ha trabajado principalmente en la línea de oncología molecular en el Instituto Maimónides de Investigación Biomédica de Córdoba (IMIBIC), participando en cuatro proyectos competitivos, con trece artículos publicados en revistas indexadas y un capítulo de libro. Ha realizado estancias científicas en Wellcome Trust Centre for Cell Biology, Universidad de Edimburgo, Escocia. Tiene experiencia docente en asignaturas como Biología Molecular, Genética, Biología Celular, etc. impartidas en diferentes Grados, con más de siete años de experiencia universitaria. Además, ha dirigido TFMs, participado en numerosos congresos y ha recibido premios y reconocimientos académicos (tres de ellos con carácter internacional). - Teresa Fuertes Novella
Profesora del Departamento de Ciencias de la Salud de la Facultad de Ciencias Biomédicas de la Universidad Europea de Madrid (UEM). Graduada en Biotecnología por la Universidad de Zaragoza, Máster en Biomedicina Molecular y Doctora en Biociencias Moleculares por la Universidad Autónoma de Madrid. Realizó su investigación predoctoral en el Centro Nacional de Investigaciones Cardiovasculares (CNIC), centrada en el desarrollo de nuevas estrategias terapéuticas para el linfoma de células B y en el estudio de la respuesta inmune frente a infecciones virales en modelos murinos. Posteriormente, llevó a cabo una estancia postdoctoral en la Universidad Complutense de Madrid. Además, cuenta con un Máster en Industria Farmacéutica por Farma Leaders Talento, formación que le permitió incorporarse al Departamento Médico de Pfizer, donde trabajó durante un año en el área de vacunas. Autora de 4 artículos científicos, publicados en revistas indexadas, y ha presentado diversas comunicaciones orales y tipo póster en diversos congresos nacionales e internacionales. Docente de Inmunología, Microbiología, Iniciación al Trabajo de Laboratorio y Biotecnología Farmacéutica en los grados de Farmacia tanto en modalidad presencial como semipresencial, Nutrición, Odontología y Biotecnología. - Rubén Ramírez Rodríguez
El profesor Rubén Ramírez Rodríguez es Licenciado en Biología por la Universidad de Salamanca, Máster en Biología y Conservación de la Biodiversidad por la Universidad de Salamanca, título propio de Máster en “Técnicas actuales de estadística aplicada” por la Universidad Nacional de Educación a Distancia (UNED), título propio de Máster en “Data Science” por la Universidad de Alcalá, y Doctor en Botánica dentro del programa de doctorado “Biología y Conservación de la Biodiversidad” por la Universidad de Salamanca. Está acreditado por ANECA como profesor Contratado Doctor y Profesor de Universidad Privada. Posee experiencia profesional en las áreas de botánica, ecología y conservación de la biodiversidad, habiendo trabajado en empresas como Ambium consultores S.L. y Tragsatec. En cuanto a su actividad investigadora, ha trabajado en las líneas de conservación de la biodiversidad, taxonomía vegetal, etnobotánica, sistemas planta-polinizador, biología reproductiva, demografía, modelos de distribución de especies (MDEs), diversidad genética, biología evolutiva, fitosociología, biogeografía, ecología vegetal, y ecología del paisaje en Universidades como Salamanca y Oviedo (España) y la Universidad de Trás-os-Montes e Alto Douro -UTAD- (Portugal), participando en 8 proyectos/contratos de investigación nacionales/internacionales, con un total de 41 publicaciones científicas (17 en JCR). Ha realizado estancias científicas en la Universidad de Trás-os-Montes e Alto Douro -UTAD- (Portugal). Tiene experiencia docente en asignaturas como Evaluación ambiental, Ecología, Ecología y Climatología, Botánica, Experimentación en biotecnología, Botánica, y Biología II impartidas en los Grados de Biología, Ingeniería forestal y del medio natural, Biotecnología, Nutrición Humana y Dietética y Medio ambiente y sostenibilidad, con más de 6 años de experiencia universitaria. Además, ha dirigido una tesis doctoral, un alumno dentro del programa JAE -becas de introducción a la investigación- del CSIC, 4 TFMs y 9 TFGs. Ha participado en un comité de tesis como secretario, y en 3 tribunales de grado (dos de ellos como presidente y otro como vocal). Ha presentado un total de 16 comunicaciones en congresos nacionales/internacionales. Premio de investigación “Jussieu Research Prize Botany Letters” en 2018 por el mejor artículo publicado en la revista “Botany Letters” en 2017 - Raquel Madrid García
La profesora Raquel Madrid es Licenciada en Biología por la Universidad de Alcalá de Henares, Máster Interuniversitario en Genética y Biología Celular por la Universidad Autónoma de Madrid, Complutense de Madrid y Universidad de Alcalá, y Doctor en Veterinaria por la Universidad Complutense de Madrid. Posee experiencia profesional en el área de la docencia, administración y seguridad habiendo trabajado en la Universidad Complutense, Universidad Europea, Universidad de Alcalá y en la empresa Croma GioBatta. En cuanto a su actividad investigadora, ha trabajado en la línea de ingeniería de proteínas y seguridad alimentaria en departamento de Nutrición y Ciencia de los Alimentos de la Universidad Complutense de Madrid. También ha trabajado en la línea de senescencia de células auditivas en el centro de investigación Fundación para la Investigación Biomédica Hospital de Getafe. Ha participado en 4 proyectos competitivos, con 16 artículos publicados en revistas indexadas y 2 capítulos de libros. Ha realizado estancias científicas en School of Biosciences en la University of Nottingham en Reino Unido. Tiene experiencia docente en asignaturas como Higiene, Inspección y Seguridad Alimentaria (prácticas) del grado de Veterinaria y de Nutrición y Ciencia de los Alimentos con más de 4 años de experiencia universitaria. También tiene experiencia en las asignaturas de Procesos Biológicos II y III, Estructura y Función, Anatomía e Informática de los grados de Farmacia, Biomedicina, Nutrición y Biotecnología de la Universidad Europea de Madrid. Además, ha participado en 3 congresos internacionales. - Ignacio Baquedano Mozos
El profesor Ignacio Baquedano Mozos es licenciado en Biología por la Universidad Complutense de Madrid, Máster en Biotecnología por la Universidad Autónoma de Madrid, y Doctor en Biociencias Moleculares por la Universidad Autónoma de Madrid. Está acreditado por ANECA como Profesor Ayudante Doctor. Posee experiencia profesional en el área de Microbiología Molecular y Biotecnología, habiendo trabajado en empresas como el Consejo Superior de Investigaciones Científicas, la Universidad Autónoma de Madrid, la Universidad de Alicante y finalmente, la Universidad Europea.
En cuanto a su actividad investigadora, ha trabajado en los siguientes proyectos: descubrimiento de proteínas de recombinación bacterianas en el Centro Nacional de Biotecnología, descubrimiento de sistemas novedosos de transferencia horizontal de genes en bacterias termófilas en el Centro de Biología Molecular Severo Ochoa, descubrimiento de nuevos sistemas CRISPR-Cas en la Universidad de Alicante y finalmente también en líneas relacionadas con la biotecnología en el Centro de Investigaciones Biológicas Margarita Salas. Ha publicado nueve artículos en revistas indexadas y tiene dos patentes. Además, ha realizado una estancia científica en la Universidad de Sherbrooke, Canadá. En cuanto a la experiencia docente, tiene acumuladas más de 250 horas impartidas distribuidas entre el Grado de Biología en la Universidad Autónoma de Madrid como en el de Farmacia en la Universidad Europea así como en el Máster de Biomedicina y el de Nutrición en la Universidad de Alicante. Por último, ha asistido a numerosos congresos, tanto nacionales como internacionales en los que ha presentado diversos posters y charlas. Así mismo ha estado involucrado en actividades de divulgación científica como la Noche Europea de los Investigadores. - Miguel Carbonell Colomer
El profesor Miguel Carbonell Colomer es Graduado en Grado en Farmacia, Grado en Nutrición por la Universidad Complutense de Madrid, y Máster en Investigación y comercialización del medicamento por la Universidad Autónoma de Madrid (Fundación Teófilo Hernando).
Cuenta con experiencia en el área de Inteligencia artificial, habiendo trabajado en Savana como HOS en el reclutamiento de IPs para estudios ecológicos con IA. En sus más de 2 años de experiencia como docente universitario, ha impartido varias asignaturas en diversos grados, tales como Farmacogenómica y Procesos biológicos en el grado de Farmacia; Farmacología en el grado de Odontología y en el grado de Enfermería; Microbiología, Anatomía y Fisiología I y II en el grado de Odontología, y Fundamentos Bioquímicos de Nutrición en el grado de Enfermería. Además, ha dirigido más de 10 TFGs y 2 TFMs. - María Hidalgo Jerez
Maria Hidalgo Jerez, PhD. Profesora Doctora en el Departamento de Farmacia y Nutrición.
Doctora en Nutrición y Tecnología de los Alimentos (programa de doctorado en Ciencias Veterinarias) por la Universidad Complutense de Madrid y CSIC (UCM-CSIC). Licenciada en "Ciencia y Tecnología de los Alimentos" y Diplomada en “Nutrición Humana y Dietética” (UCM). Postgrado del “Tratamiento dietético del sobrepeso y la obesidad”, Universidad de Barcelona IL-3, (UB IL-3). Título propio Universitario de Fitoterapia, Universidad Europea Miguel de Cervantes. Título de experto en Nutrición Deportiva, EVEA, Madrid. Curso de Formación de auditores de sistemas de gestión de la calidad en la industria agroalimentaria (UNE-EN-ISO 19011) como auditor de BRC, ACOFESAL y La Cámara de Madrid, Madrid. Estancia formativa y práctica en el área de “Polifenoles y Microbiota” en “Department of Food and Nutritional Sciences” Reading, Berkshire, Buckinghamshire and Oxfordshire, United Kingdom. Cuenta con experiencia investigadora en el Instituto de Ciencia y Tecnología de los Alimentos y Nutrición (ICTAN, CSIC) y experiencia en Industria Alimentaria privada como Directora de I+D+i, Formulación galénica, Seguridad Alimentaria y Documentación Regulatoria. Autora de diez artículos en revistas de alto impacto y contribución a 7 congresos nacionales e internacionales. Autora de asignaturas del área de la Nutrición y Tecnología de los Alimentos (Funiber), formadora de manipuladores de alimentos y experiencia docente en “Alimentación deportiva” en la Universidad Obreta de Catalunya, UOC- Barcelona y “Ayudas ergogénica para la salud y el deporte” en la Academia Española de Nutrición Humana y Dietética. En los últimos años ha impartido docencia en el área de Tecnología y Seguridad Alimentaria, Bromatología, Nutrición Clínica y Deportiva. Además, ha dirigido varios TFG y TFM en las áreas donde es experta. - Alessandra Maestri
La profesora Alessandra Maestri es Licenciada en Farmacia por la Universidad de Milán y Graduada en Nutrición Humana y Dietética por la Universidad Europea de Madrid. Posee una Diplomatura en Biotecnología Farmacéutica por la Universidad de Milán y un Máster Oficial en Nutrición Clínica por la Universitat Oberta de Catalunya. Actualmente es doctoranda en Biomedicina y Ciencias de la Salud en la Universidad Europea de Madrid.
Posee una sólida trayectoria en el sector de la industria farmacéutica, habiendo trabajado en empresas líderes como Sanofi y Pfizer. Cuenta además con experiencia en el ámbito clínico y sanitario, desarrollando su actividad como farmacéutica comunitaria y dietista-nutricionista.
En cuanto a su actividad investigadora, ha participado en proyectos experimentales en el grupo de Biotransformaciones del Departamento de Química Orgánica y Farmacéutica de la Universidad Complutense de Madrid y en la Universidad de Milán. Actualmente desarrolla su trabajo doctoral en el marco del proyecto GutPlantHealth, desarrollado por el Instituto IMDEA Nutrición y la Universidad Europea de Madrid.
Tiene experiencia docente en asignaturas como Dietética, Farmacología, Farmacognosia y Botánica Farmacéutica, impartidas en los grados de Nutrición Humana y Dietética, Odontología y Farmacia.
Excelencia avalada por los mejores
Preguntas frecuentes
¿Qué es el Grado en Farmacia?
Es una carrera universitaria de 5 años y 300 créditos europeos (ECTS) que integra formación científica con práctica clínica y que te capacita como farmacéutico. Combina asignaturas de química, biología, farmacología y tecnología farmacéutica con prácticas en laboratorio y estancias en farmacias y hospitales.
¿Dónde se realizan las prácticas en la carrera de Farmacia?
Las prácticas obligatorias se realizan en farmacias comunitarias, hospitales y laboratorios de la industria farmacéutica. Tienen una duración aproximada de seis meses. Son requisito para obtener el título de farmacéutico.
¿Qué perfil debe tener un estudiante de farmacia?
Se recomienda tener interés por la química, la biología y la salud. También es importante la precisión, la responsabilidad y la capacidad de comunicación con pacientes.
¿Qué funciones tiene un farmacéutico en el sistema sanitario?
El farmacéutico se encarga de dispensar medicamentos y asesorar sobre su correcto uso al cliente.También participa en programas de salud pública, control de tratamientos y seguimiento farmacoterapéutico. Además, puede trabajar en investigación y desarrollo de nuevos fármacos.
¿Qué oportunidades ofrece farmacia en investigación?
La farmacia permite trabajar en el desarrollo de medicamentos, ensayos clínicos y biotecnología farmacéutica. También abre la puerta a carreras académicas en universidades y centros de investigación. Es un área con gran proyección internacional.
¿Qué diferencia hay entre un farmacéutico hospitalario y uno comunitario?
El farmacéutico comunitario trabaja en farmacias de calle, dispensando y asesorando a pacientes. El hospitalario se integra en equipos médicos para el control y seguimiento de tratamientos en hospitales.
¿Qué máster puedo estudiar después del Grado en Farmacia?
Puedes especializarte en investigación, industria farmacéutica, biotecnología, salud pública o docencia. El acceso al FIR (Farmacéutico Interno Residente) permite especializarse en farmacia hospitalaria.